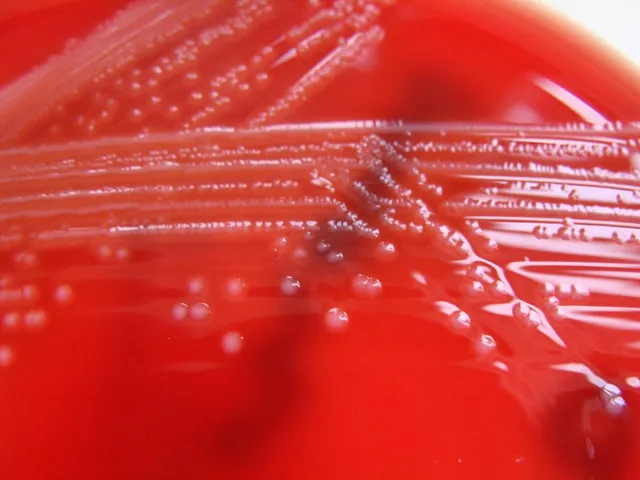
Pferdeblut in der Pharmaindustrie

"AI & Animals" – Wenn das Schicksal von Tieren von KI bestimmt wird
Was passiert, wenn in der Massentierhaltung Algorithmen entscheiden?
Filmtipp von Anne
26.03.2026

Letzte Woche bin ich auf eine Zahl gestoßen, die mich seitdem nicht loslässt: 500 Millionen. So viele Hühner sterben jedes Jahr allein auf den Geländen von Farmen in den USA, bevor sie überhaupt den Schlachthof erreichen. Keine erfasste Todesursache, kein Eintrag, nichts. Einfach weg. Der Bericht von Animal Equality, der diese Zahlen aus USDA-Daten destilliert hat, trägt den passenden Titel: "Uncounted" 1.
Ich saß also da, schaute auf meinen Bildschirm und fragte mich: Was passiert, wenn künftig nicht mehr Menschen, sondern Algorithmen über das Schicksal von Milliarden Tieren entscheiden? Ohne öffentliche Diskussion, ohne Regulierung, ohne jemanden, der überhaupt hinschaut?
Genau diese Frage stellt auch der neue Dokumentarfilm "AI & Animals" – mit großer Dringlichkeit. Produziert hat das Werk Animal Ethics; 2 Regie geführt haben Alba García Bernal und Óscar Horta; Xiana Castro hat sich um Kamera und Schnitt gekümmert. Die Synchronsprecherin Samantha Damiano, die zuletzt in der Doku "Seantience" (2025) 3 zu hören war, hat "AI & Animals" eingesprochen. Ihr könnt euch die Doku kostenlos auf der Webseite oder auf dem YouTube-Kanal zum Film 4 ansehen oder direkt hier bei mir. Ich habe euch das Video unter diesen Artikel gesetzt.
Vorsicht: Der Film könnte dazu führen, dass du die nächsten Stunden damit verbringst, dir ernsthafte Sorgen um die Zukunft zu machen. Aber das ist genau der Punkt.
Das laute Schweigen im Raum
Seit Jahren dreht sich die öffentliche Debatte über künstliche Intelligenz und Large Language Models (LLMs) um ein paar immer gleiche Themen: Jobs, Desinformation, Urheberrecht, vielleicht noch Datenschutz. Tiere fallen dabei bis heute komplett unter den Tisch, weil sie schlicht niemand auf dem Schirm zu haben scheint.
"AI & Animals" stellt daher die Frage, wie es weitergehen soll. Der Film beendet das Schweigen im Raum, das immer lauter zu werden scheint. Während Tierhaltungsbetriebe bereits heute weltweit KI-Systeme einsetzen, hat die globale Debatte über LLMs noch kaum begonnen. Dabei ist es so wichtig, der Sache nachzugehen und zu hinterfragen, was diese Technologie für nichtmenschliche Lebewesen bedeutet. Das Filmteam spricht von einem "limited window of time", einem begrenzten Zeitfenster, in dem wir noch die Wahl haben, welchen Weg die Entwicklung nimmt.
Animal Ethics bringt das Kernproblem auf den Punkt. Beim Lesen bin ich förmlich zusammengezuckt:
"We failed to prevent factory farming before it became entrenched. We failed to stop industrial fish farming before billions suffered in cramped conditions. We failed to anticipate insect farming's explosive growth. With AI, we cannot afford to make the same mistake." 5 ("Wir haben es versäumt, die Massentierhaltung zu verhindern, bevor sie sich festgesetzt hat. Wir haben es versäumt, die industrielle Fischzucht zu stoppen, bevor Milliarden von Tieren in beengten Verhältnissen leiden mussten. Wir haben das explosive Wachstum der Insektenzucht nicht kommen sehen. Mit KI können wir uns denselben Fehler nicht leisten.")
Und da ist es wieder, das altvertraute Muster. Wir reagieren erst, wenn es längst zu spät ist.
Das Albtraum-Szenario: Massentierhaltung im Zeitalter der KI
Der Film entwirft zwei mögliche Versionen der Zukunft und beginnt mit der unangenehmeren.
Im ersten Szenario werden KI-Systeme zu einem unsichtbaren Beschleuniger für die Intensivtierhaltung. Schon heute gibt es Unternehmen, die damit werben, dank KI mehr Tiere pro Quadratmeter Stallboden halten zu können. Die Doku zeigt, wie Algorithmen in der Tierhaltung aktuell primär darauf ausgelegt sind, Produktion zu maximieren und Kosten zu minimieren, anstatt das Wohlergehen der Tiere zu verbessern. Es geht nicht um ethische Abwägung oder darum, ob etwas richtig oder falsch oder vertretbar ist, sondern einzig und allein um eines: Effizienz.
Der Albtraum beginnt. Millionen von Tieren, die überwacht von KI-Systemen in immer dichter gedrängten Haltungssystemen ohne nennenswerte menschliche Überwachung gehalten werden. Die ethische Verantwortung wird sozusagen wegautomatisiert.
Sam Tucker, Gründer von Open Paws, einer Organisation, die KI-Tools gezielt für Tierrechtsorganisationen entwickelt, formuliert es im Film so:
"The future of AI is at a crossroads — a tug-of-war between being used to harm animals through intensified factory farming or to help them through powerful advocacy." ("Die Zukunft der KI steht an einem Scheideweg — ein Tauziehen zwischen dem Einsatz zum Schaden von Tieren durch intensivierte Massentierhaltung und dem Einsatz zu ihrem Nutzen durch wirkungsvolle Interessenvertretung.")
Eine weitere Gefahr, die "AI & Animals" benennt, ist die Frage der eingebetteten Werte. LLMs lernen aus dem Internet. Und das ist bekanntlich stark von Speziesismus geprägt. Wenn KI-Systeme diese Verzerrungen übernehmen und verstärken, könnten sie die Diskriminierung nichtmenschlicher Lebewesen nicht nur fortbestehen lassen, sondern systematisch zementieren. Der Film diskutiert dabei explizit auch die besonders vernachlässigten Gruppen: Wirbellose, Fische, Tiere in Aquakulturen, sprich, genau jene, um die sich die Debatte ohnehin schon viel zu wenig dreht.
Die Hoffnung: Was KI für Tiere tun könnte
Zum Glück endet "AI & Animals" nicht bei der Schreckensvision, sondern stellt ihr ein positiveres Szenario gegenüber, von dem ich mich, offen gesagt, kaum zu hoffen wage. KI dient der Menschheit darin als Werkzeug, das das Leid von Tieren aktiv zu mildern. Der Film skizziert dafür verschiedene konkrete Möglichkeiten.
KI könnte dabei helfen, Tierkrankheiten in Farmbetrieben frühzeitig zu erkennen und zu verhindern. So könnte beispielsweise der Einsatz von Antibiotika auf Dauer verringert und der Gefahr der Antibiotikaresistenz entgegengewirkt werden. Sie könnte Wildtiere schützen, indem sie Schmuggel oder Lebensraumverlust besser überwacht. Sie könnte Alternativen zu Tierversuchen in der Forschung vorantreiben und, das vielleicht Aufregendste, tatsächlich dabei helfen, die Sprachen der Tiere zu entschlüsseln.
Das klingt nach Science-Fiction, ist jedoch näher als gedacht: KI-Modelle, die Walgesänge analysieren, haben bereits erste Fortschritte in Richtung Übersetzung gemacht. Was würde es bedeuten, wenn wir irgendwann wirklich verstehen könnten, was Tiere kommunizieren wollen?
Der Film argumentiert außerdem, dass KI-Tools, richtig eingesetzt, die Tierschutzbewegung selbst stärken können. Sie könnten unter anderem Advocacy-Organisationen effizienter machen, ihre Reichweite vergrößern und ihnen helfen, auf Augenhöhe mit einer Industrie zu agieren, die KI längst für sich nutzt. Proaktiv statt reaktiv, quasi.
Die Stimmen hinter dem Film
Insgesamt 16 Forscherinnen, Philosophen, Strategistinnen und Aktivistinnen kommen in "AI & Animals" zu Wort 6. Darunter einige sehr bekannte Tierrechtsaktivist*innen:
- Oscar Horta (Universität Santiago de Compostela) ist Co-Regisseur des Films. Der Mitgründer von Animal Ethics ist einer der prominentesten Antispeziesismus-Philosoph*innen. Sein 2022 bei Routledge erschienenes Buch "Making a Stand for Animals" gilt als eines der zugänglichsten und gleichzeitig argumentativ stärksten Werke der zeitgenössischen Tierethik. Er legt darin die philosophische Grundlage für vieles, was der Film behandelt.
- Bernice Bovenkerk (Wageningen University & Research) ist Professorin für Tier- und Umweltethik an einer Institution, die weltweit vor allem für ihre Agrar- und Lebenswissenschaften bekannt ist. Ihre laufende Forschung trägt den Titel "The Promise and Perils of Digital Technology for Human-Animal Relationships" und bewegt sich damit thematisch sehr nah am Kern der neuen Doku.
- Matti Wilks (Universität Edinburgh) ist Psychologin und erforscht, wie und warum Menschen ihren moralischen Kreis ausweiten. Also wem wir unsere moralische Berücksichtigung überhaupt zukommen lassen. Mit ihrer in "Psychological Science" veröffentlichten, viel beachteten Studie von 2021 zeigte sie auf, dass Kinder Tiere deutlich weniger selbstverständlich geringer gewichten als Erwachsene. Damit legte sie unter anderem nahe, dass Speziesismus kein angeborener Instinkt ist, sondern erlernt wird.
- Jonathan Birch (London School of Economics) ist Autor von "The Edge of Sentience". Er erforscht die Grenzen des Bewusstseins und der Leidensfähigkeit bei Tieren und damit genau das, was für KI-Ethik im Kontext von Tierhaltung entscheidend ist.
- Jeff Sebo (New York University) ist Mitautor von "Saving Animals, Saving Ourselves". Er ist einer der wenigen Philosophen, die die Verbindung zwischen KI, Klimakrise und Tierrechten schon länger als dringlich betrachten.
Neben den Genannten sind u. a. Vertreter*innen von Animal Charity Evaluators, Sentient Futures, der Wageningen University, der National University of Singapore und der Universität Edinburgh dabei. Es handelt sich also um ein sehr internationales Panel.
Wie soll es jetzt weitergehen?
Samantha Damiano bringt mit ihrer Narration den zentralen Appell des Films auf den Punkt:
"The stakes could not be higher. If we don't start working on this right away, it may soon be too late to make a difference. Animals need us to take this task seriously. Not next decade, not in a few years, but now." ("Der Einsatz könnte nicht höher sein. Wenn wir nicht sofort damit beginnen, daran zu arbeiten, könnte es bald zu spät sein, um noch etwas bewirken zu können. Die Tiere brauchen uns, damit wir diese Aufgabe ernst nehmen. Nicht im nächsten Jahrzehnt, nicht in ein paar Jahren, sondern jetzt.")
Das ist kein übertriebener Alarmismus, sondern die logische Konsequenz aus allem, was wir in den vergangenen Jahrzehnten falsch gemacht haben. Wir haben es beim Thema Massentierhaltung genauso versaut wie bei der Fisch- und Insektenzucht. Und warum? Weil wir immer erst reagieren, wenn sich die Strukturen bereits so tief eingefressen haben, dass eine Veränderung kaum noch möglich ist.
Das Zeitalter der KI befindet sich noch am Anfang. Genau das macht diesen Moment so selten und so wichtig. Und wir müssen handeln, denn die Entwicklung lässt sich nicht mehr aufhalten und sie findet so rasend schnell statt, dass das menschliche Gehirn sie schon heute nicht mehr erfassen kann.